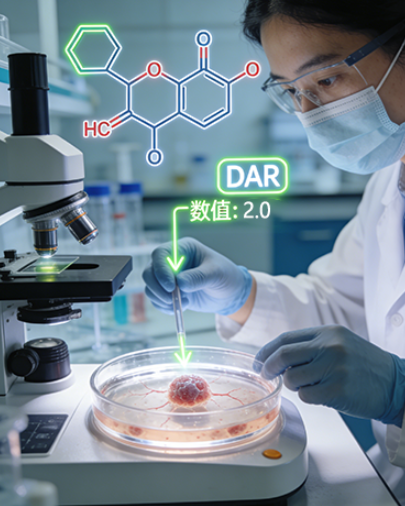
定制HER2靶向ADC

西安齐岳生物深耕生物偶联技术研发领域,搭建成熟的ADC抗体偶联定制平台,专注为全球科研机构、药企及研发企业提供抗体-药物偶联物(ADC)一站式定制服务,覆盖临床前科研、药物筛选、IVD试剂开发等多场景,凭借专业的偶联工艺、严格的质控体系与丰富的项目经验,为ADC药物研发、靶向递送研究提供高品质原料与全链条技术支持,助力科研与产业化项目高效推进。
一、ADC定制核心定位
抗体-药物偶联物(ADC)作为靶向* 领域的核心方向,由抗体、连接子(Linker)和小分子细胞毒药物(SM)三部分组成,通过抗体的靶向识别作用将细胞毒药物精准递送至靶细胞,实现“靶向杀伤”,降低对正常组织的损伤。西安齐岳生物聚焦ADC定制核心需求,依托自身合成与表征能力,可根据客户具体研发诉求,量身定制专属ADC产品及技术方案,兼顾产物活性、均一性与安全性,适配不同研发阶段的多样化需求,同时参考行业前沿研究成果,优化定制工艺,提升产品竞争力。

二、核心定制能力与优势
(一)全方位偶联技术支撑
依托专业研发团队,熟练掌握多种偶联技术,可实现抗体与各类小分子的高效、定点偶联,核心优势如下:
核心支撑 | 具体内容 |
主流偶联工艺 | 擅长Seattle Genetics方法(基于半胱氨酸)、Immunogen方法(基于赖氨酸),同时掌握GlyCLICK®定点偶联技术,实现精准偶联 |
偶联方式 | 支持半胱氨酸偶联(-SH)、赖氨酸偶联(-NH2)等多种类型,可利用Mal-PEG-NHBoc实现定点、可控的多功能修饰 |
质量控制 | 精准控制药物抗体比(DAR),确保产物均一性,规避非特异性偶联带来的质量波动,同时规避ADC相关不良反应风险 |
(二)全链条定制服务覆盖
提供从分子设计、原料合成到产物纯化、表征检测的全流程定制服务,无需客户多渠道对接,大幅提升研发效率,具体覆盖ADC三大核心组成部分:
ADC组成部分 | 定制范围 |
抗体端 | 提供多种靶点抗体的筛选与修饰,涵盖HER2、TROP2等热门靶点,适配不同肿瘤类型研发需求 |
连接子(Linker) | 可定制可降解(酯键、二硫键)、不可降解(酰胺键、醚键)、响应型(pH响应、酶响应)等多种类型,适配不同递送需求 |
小分子细胞毒药物(SM) | 实现精准偶联,同时保留药物活性,涵盖多柔比星、美登素等主流毒素分子,可定制荧光探针偶联产品 |
(三)灵活的规模与纯度定制
聚焦不同研发阶段需求,提供灵活的规模与纯度定制,具体如下:
• 定制规模:可灵活承接毫克级至克级定制,覆盖1毫克到10克生产规模,同时可提供肝癌细胞膜包被类ADC相关纳米粒定制(如HCCM@PBNPs),适配科研及中试需求
• 适配场景:完美适配实验室研发、小试、中试等不同阶段需求,覆盖临床前科研、药物筛选、IVD试剂开发等多场景
• 交付优势:生产流程稳定,可保障定制产物的纯度与活性,满足不同研发场景的核心诉求,参考行业CDMO服务标准优化交付流程
三、具体定制产品
西安齐岳生物ADC定制产品涵盖科研级、小试级、中试级,聚焦热门靶点与主流技术路线,部分核心定制产品如下,可根据客户需求灵活调整参数:
产品类型 | 具体产品 | 适配场景 |
科研级ADC | HER2靶向ADC(Trastuzumab-药物偶联物) | 实验室靶向杀伤研究 |
科研级ADC | TROP2靶向ADC(Sacituzumab-药物偶联物) | 肿瘤细胞筛选实验 |
小试级ADC | CD33靶向ADC(Gemtuzumab-药物偶联物) | 小试工艺验证 |
特色定制产品 | HCCM@PBNPs肝癌靶向偶联纳米粒 | 肝癌靶向成像与研究 |
偶联原料定制 | Mal-PEG-NHBoc偶联试剂 | ADC原料自主合成 |
四、定制案例分享
定制案例 | 客户需求 | 相关图示 |
某高校HER2阳性乳腺癌ADC科研定制项目 | 定制HER2靶向ADC,用于乳腺癌细胞体外杀伤实验,要求DAR值稳定在2.0,抗体纯度≥95%,偶联后药物活性保留率≥85%,提供完整表征报告。 | ![]() |
某药企TROP2靶向ADC小试工艺开发项目 | 针对TROP2靶点,开发ADC小试生产工艺,定制克级规模ADC产品,要求工艺可放大,DAR值波动≤±0.3,产物稳定性满足长期储存需求,规避非特异性偶联风险。 | ![]() |
某科研机构肝癌靶向偶联纳米粒定制项目 | 制肝癌细胞膜包被普鲁士蓝纳米粒(HCCM@PBNPs),用于肝癌靶向成像与光热* 研究,要求纳米粒分散性好、靶向性强,提供毫克级样品及相关特性检测报告。 | ![]() |
五、ADC定制服务流程
西安齐岳生物遵循“精准对接、标准化执行、高效交付”的服务理念,建立全流程一站式定制服务流程,全程可追溯、可沟通,确保客户需求落地,具体流程如下:
1. 需求沟通:客户提出定制需求(靶点、偶联方式、DAR值、规模、纯度、交付时间等),我方专业技术团队对接,梳理需求细节,结合行业技术进展提供合理化建议,确认定制方案与报价,参考ADC研发全流程要点优化方案细节。
2. 合同签订与预付款:双方确认定制方案后,签订正式合同,客户支付预付款,我方启动项目立项,建立专属项目档案,明确各环节时间节点与质控标准。
3. 原料准备与合成:根据定制方案,筛选、合成或采购抗体、连接子、小分子药物等核心原料,对原料进行纯度检测,确保原料合格,可提供Mal-PEG-NHBoc等偶联原料的自主合成服务。
4. ADC偶联与纯化:采用预设偶联工艺,进行ADC偶联反应,严格控制反应温度、时间等参数;通过凝胶过滤层析、HPLC等方法进行纯化,去除杂质与未偶联原料,确保产物纯度达标。
5. 表征检测:对纯化后的ADC产品进行全面表征,包括DAR值检测、纯度检测、活性检测、稳定性检测等,生成详细表征报告,同步检测偶联特异性,规避非特异性偶联风险。
6. 产品包装与交付:按照客户要求进行产品包装(真空冻干、无菌包装等),附带表征报告、使用说明书、安全说明书;客户支付尾款后,安排物流发货,确保产品运输过程中活性不受影响。
7. 售后保障:交付后提供相关售后支持,解答客户使用过程中的疑问;确保客户研发工作顺利推进。

六、参考文献
1. Chis, A. A., Dobrea, C. M., Arseniu, A. M., et al. Antibody–Drug Conjugates—Evolution and Perspectives. International Journal of Molecular Sciences, 2024, 25(13): 6969. https://doi.org/10.3390/ijms25136969
2. Ronald P. Taylor, Margaret A. Lindorfer. Antibody-drug conjugate adverse effects can be understood and addressed based on immune complex clearance mechanisms. Blood, 2024, 144(2): 137–144. https://doi.org/10.1182/blood.2024024442
3. De Goeij BE, Lambert JM. New developments for antibody-drug conjugate-based therapeutic approaches. Curr Opin Immunol, 2016, 40: 14-23.
4. Song C, Jeong M, In H, et al. Trends in the development of antibody-drug conjugates for cancer therapy. Antibodies (Basel), 2023, 12(4): 72.

齐岳微信公众号
官方微信
库存查询